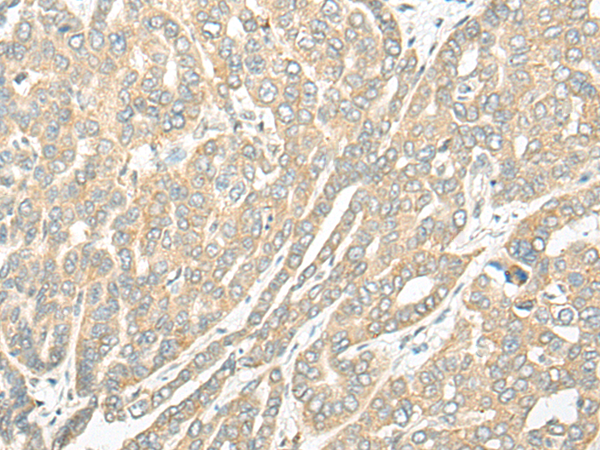

中文名稱:兔抗ROM1多克隆抗體
英文名稱: Anti-ROM1 rabbit polyclonal antibody
別 名: ROM; RP7; ROSP1; TSPAN23
相關類別: 一抗
儲 存: 冷凍(-20℃)
宿 主: Rabbit
抗 原: ROM1
反應種屬: Human, Mouse
標記物: Unconjugate
克隆類型: rabbit polyclonal
技術規格
|
Background: |
This gene is a member of a photoreceptor-specific gene family and encodes an integral membrane protein found in the photoreceptor disk rim of the eye. This protein can form homodimers or can heterodimerize with another photoreceptor, retinal degeneration slow (RDS). It is essential for disk morphogenesis, and may also function as an adhesion molecule involved in the stabilization and compaction of outer segment disks or in the maintenance of the curvature of the rim. Certain defects in this gene have been associated with the degenerative eye disease retinitis pigmentosa. |
|
Applications: |
ELISA, WB, IHC |
|
Name of antibody: |
ROM1 |
|
Immunogen: |
Fusion protein of human ROM1 |
|
Full name: |
retinal outer segment membrane protein 1 |
|
Synonyms: |
ROM; RP7; ROSP1; TSPAN23 |
|
SwissProt: |
Q03395 |
|
ELISA Recommended dilution: |
5000-10000 |
|
IHC positive control: |
Human liver cancer |
|
IHC Recommend dilution: |
30-150 |
|
WB Predicted band size: |
37 kDa |
|
WB Positive control: |
TM4, 293T, 231 and Hela cell lysates |
|
WB Recommended dilution: |
500-2000 |

購物車
購物車 幫助
幫助
 021-54845833/15800441009
021-54845833/15800441009
